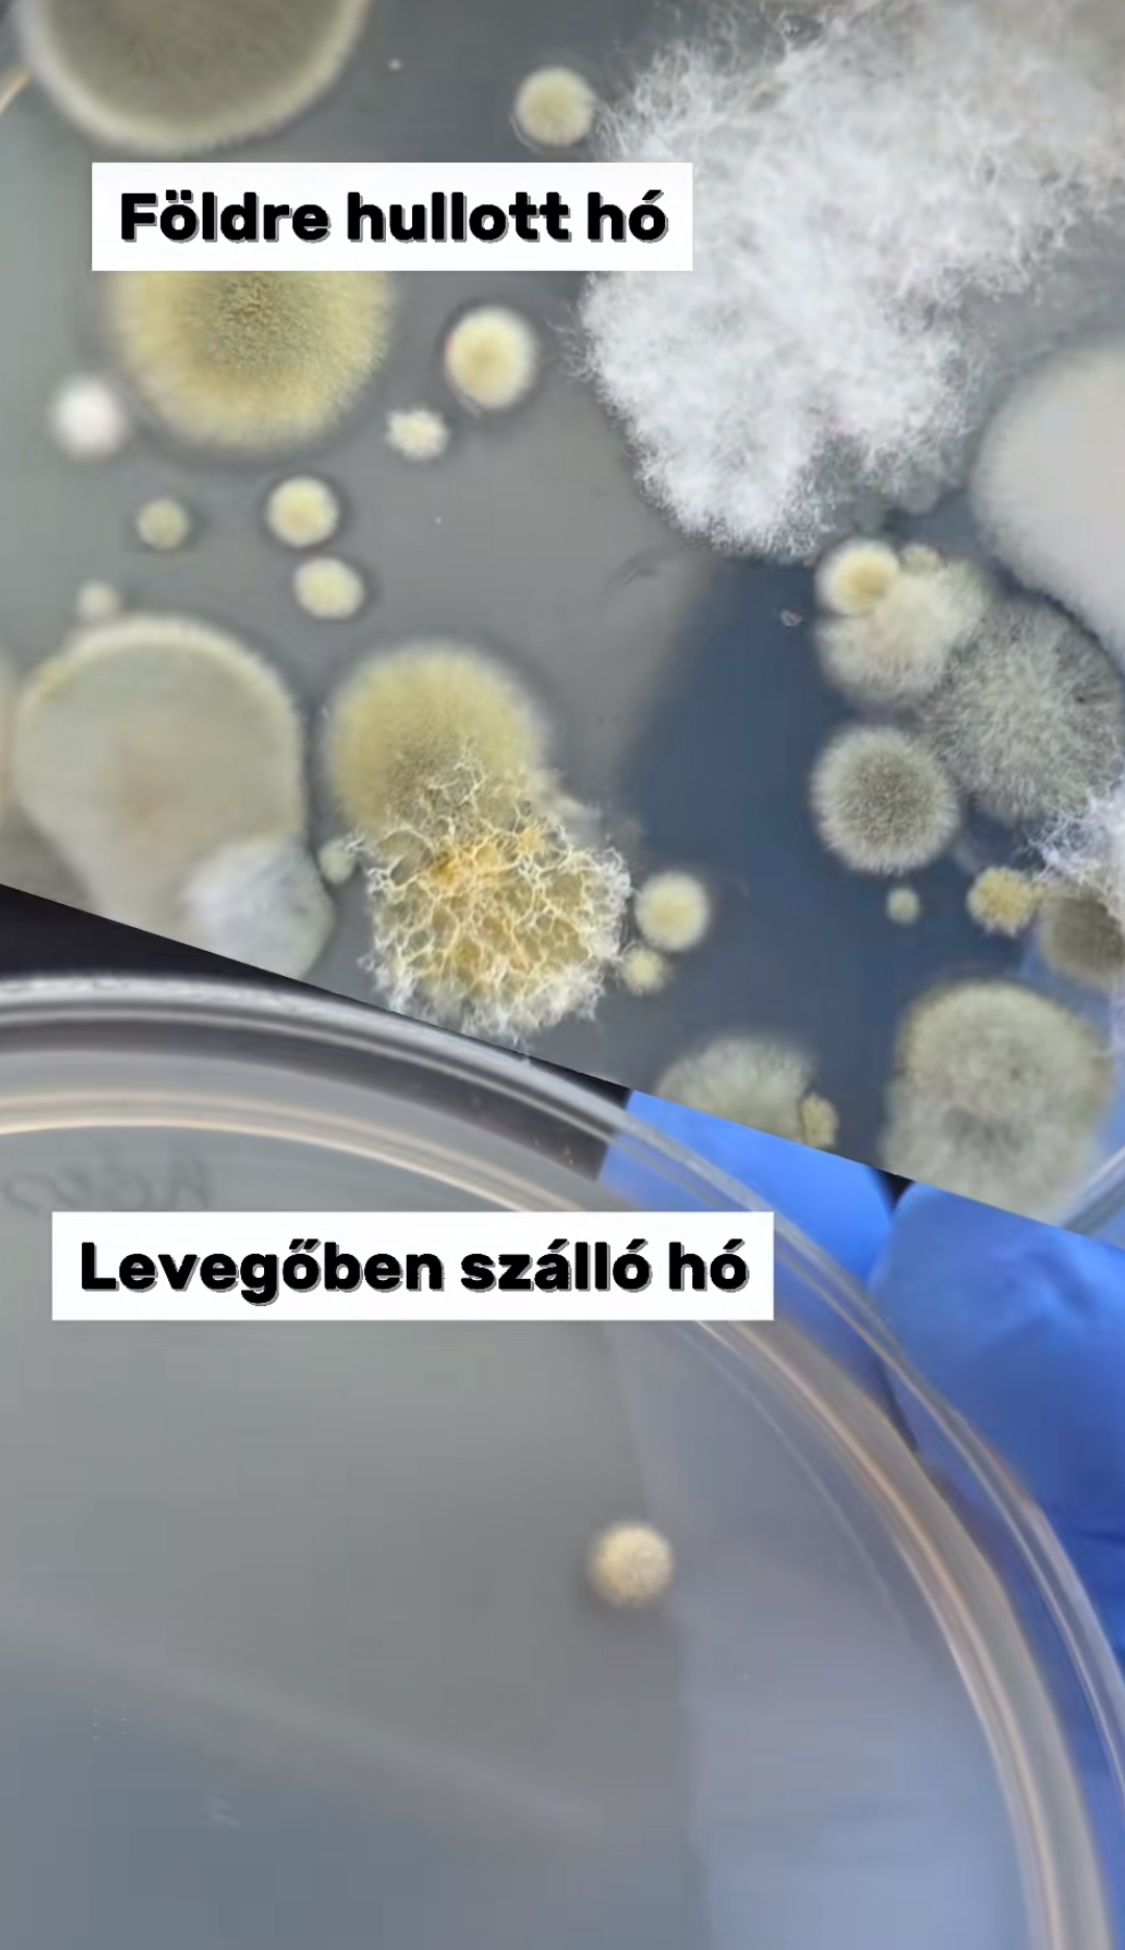

Fontos közleményt adott ki a Főügyészség Till Tamás ügye kapcsán
A kisfiút egy fiatalkorú ölte meg különös kegyetlenséggel.
Újabb érdekes kísérlettel jelentkezett Gyuris Rita növényorvos. A frissen hullott hó nem is olyan tiszta, mint amilyennek létszik? Most kiderül!
Rég nem látott mennyiségű hó hullott hazánkban, aminek voltak akik örültek, de olyanok is, akik kevésbé. A TikTok egyik kedvenc növényorvosa, Gyuris Rita letesztelte, hogy mennyire tiszta a hó. Az eredmény megdöbbentő.

„Nézzük meg, hogy mennyire tiszta a hó!” – kezdte TikTok videójában a növényorvos.
Először a lehullott hóból vettem mintát. A steril mintavevő pálcával belelapátoltam az agar-lemezbe a havat; amit háromszor is megismételtem. Megvártam, amíg elolvad és szétkentem az agar-lemezen. Azt gondolom, hogy így talán pontosabb eredményt ad, mintha csak végig simogatnám a pálcával a havat
– mondta Rita, majd a hulló hóból is mintát vett. „Kinyitottam az agar-lemezt és megvártam, amíg belehullik a hó.”
A kísérlet eredménye megdöbbentő: a lehullott hó mintájából számtalan gombatelep nőtt fel. Az eredményt a növényorvos a következőképpen magyarázza:
„A hó kémiailag viszonylag tiszta, azonban biológiailag sosem steril. A hópelyhek magjait leginkább a légkörben lévő kosz, porszem, pollenek, gombaspórák, baktériumok adják.”
A hulló hó azonban teljesen más eredményeket mutatott.
„A táptalajba szállingózó hópelyhek esetében csak egy gombatelep nőtt fel. Részben azért, mert kevesebb hóminta került a petri-csészébe, másrészt nem érintkezett talajjal, növényzettel; és nem mindegyik hópehelynek a magja gombaspóra, vagy baktérium. A lehullott hó talán azért is tartalmazhat több szennyeződést, gombaspórát, mert a talaj közelében lévő légáramlat is hozza-viszi ezeket a szennyeződéseket; a frissen hullott nedves hó pedig tárt karokkal fogadja azokat” – mondta a növényorvos, hozzátéve, hogy mindenki maga döntse el, hogy ezek után szeretne-e havat enni…

A kisfiút egy fiatalkorú ölte meg különös kegyetlenséggel.

Börtönbüntetése elől menekült Szlovákiába a bűnöző.

Elképesztő megállapítással rukkolt elő a professzor.
Nem akar lemaradni a Metropol cikkeiről? Adja meg a nevét és az e-mail címét, és mi hetente három alkalommal elküldjük Önnek a legjobb írásokat!
Feliratkozom a hírlevélrePortfóliónk minőségi tartalmat jelent minden olvasó számára. Egyedülálló elérést, országos lefedettséget és változatos megjelenési lehetőséget biztosít. Folyamatosan keressük az új irányokat és fejlődési lehetőségeket. Ez jövőnk záloga.